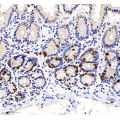
Anti-BrdU Mouse mAb (100 μl)

Your shopping cart is empty!
ServiceBio
Reactivity: Mouse Applications: WB, IHC/IF Host Species: Rabbit Clonali..
Reactivity: M & M Applications: WB & IHC/IF Host Species: Rabbit ..
Reactivity: M,R & M,R Applications: WB & IHC/IF Host Species: Mouse &n..
Reactivity: H,M,R & M,R Applications: WB & IHC/IF Host Species: Rabbit ..
Reactivity: M,R & H,M,R Applications: WB & IHC/IF Host Species: Rabbit ..
Reactivity: H,M,R & H,M,R Applications: WB & IHC/IF Host Species: Rabbit &nb..
Reactivity: All species Applications: IHC/IF Host Species: Mouse C..
Reactivity: H,M,R & H,M,R Applications: WB & IHC/IF Host Species: Rabbit &nb..
Reactivity: H,M,R & H,M,R Applications: WB & IHC/IF Host Species: Rabbit &nb..
Reactivity: M & M Applications: WB & IHC/IF Host Species: Rabbit ..